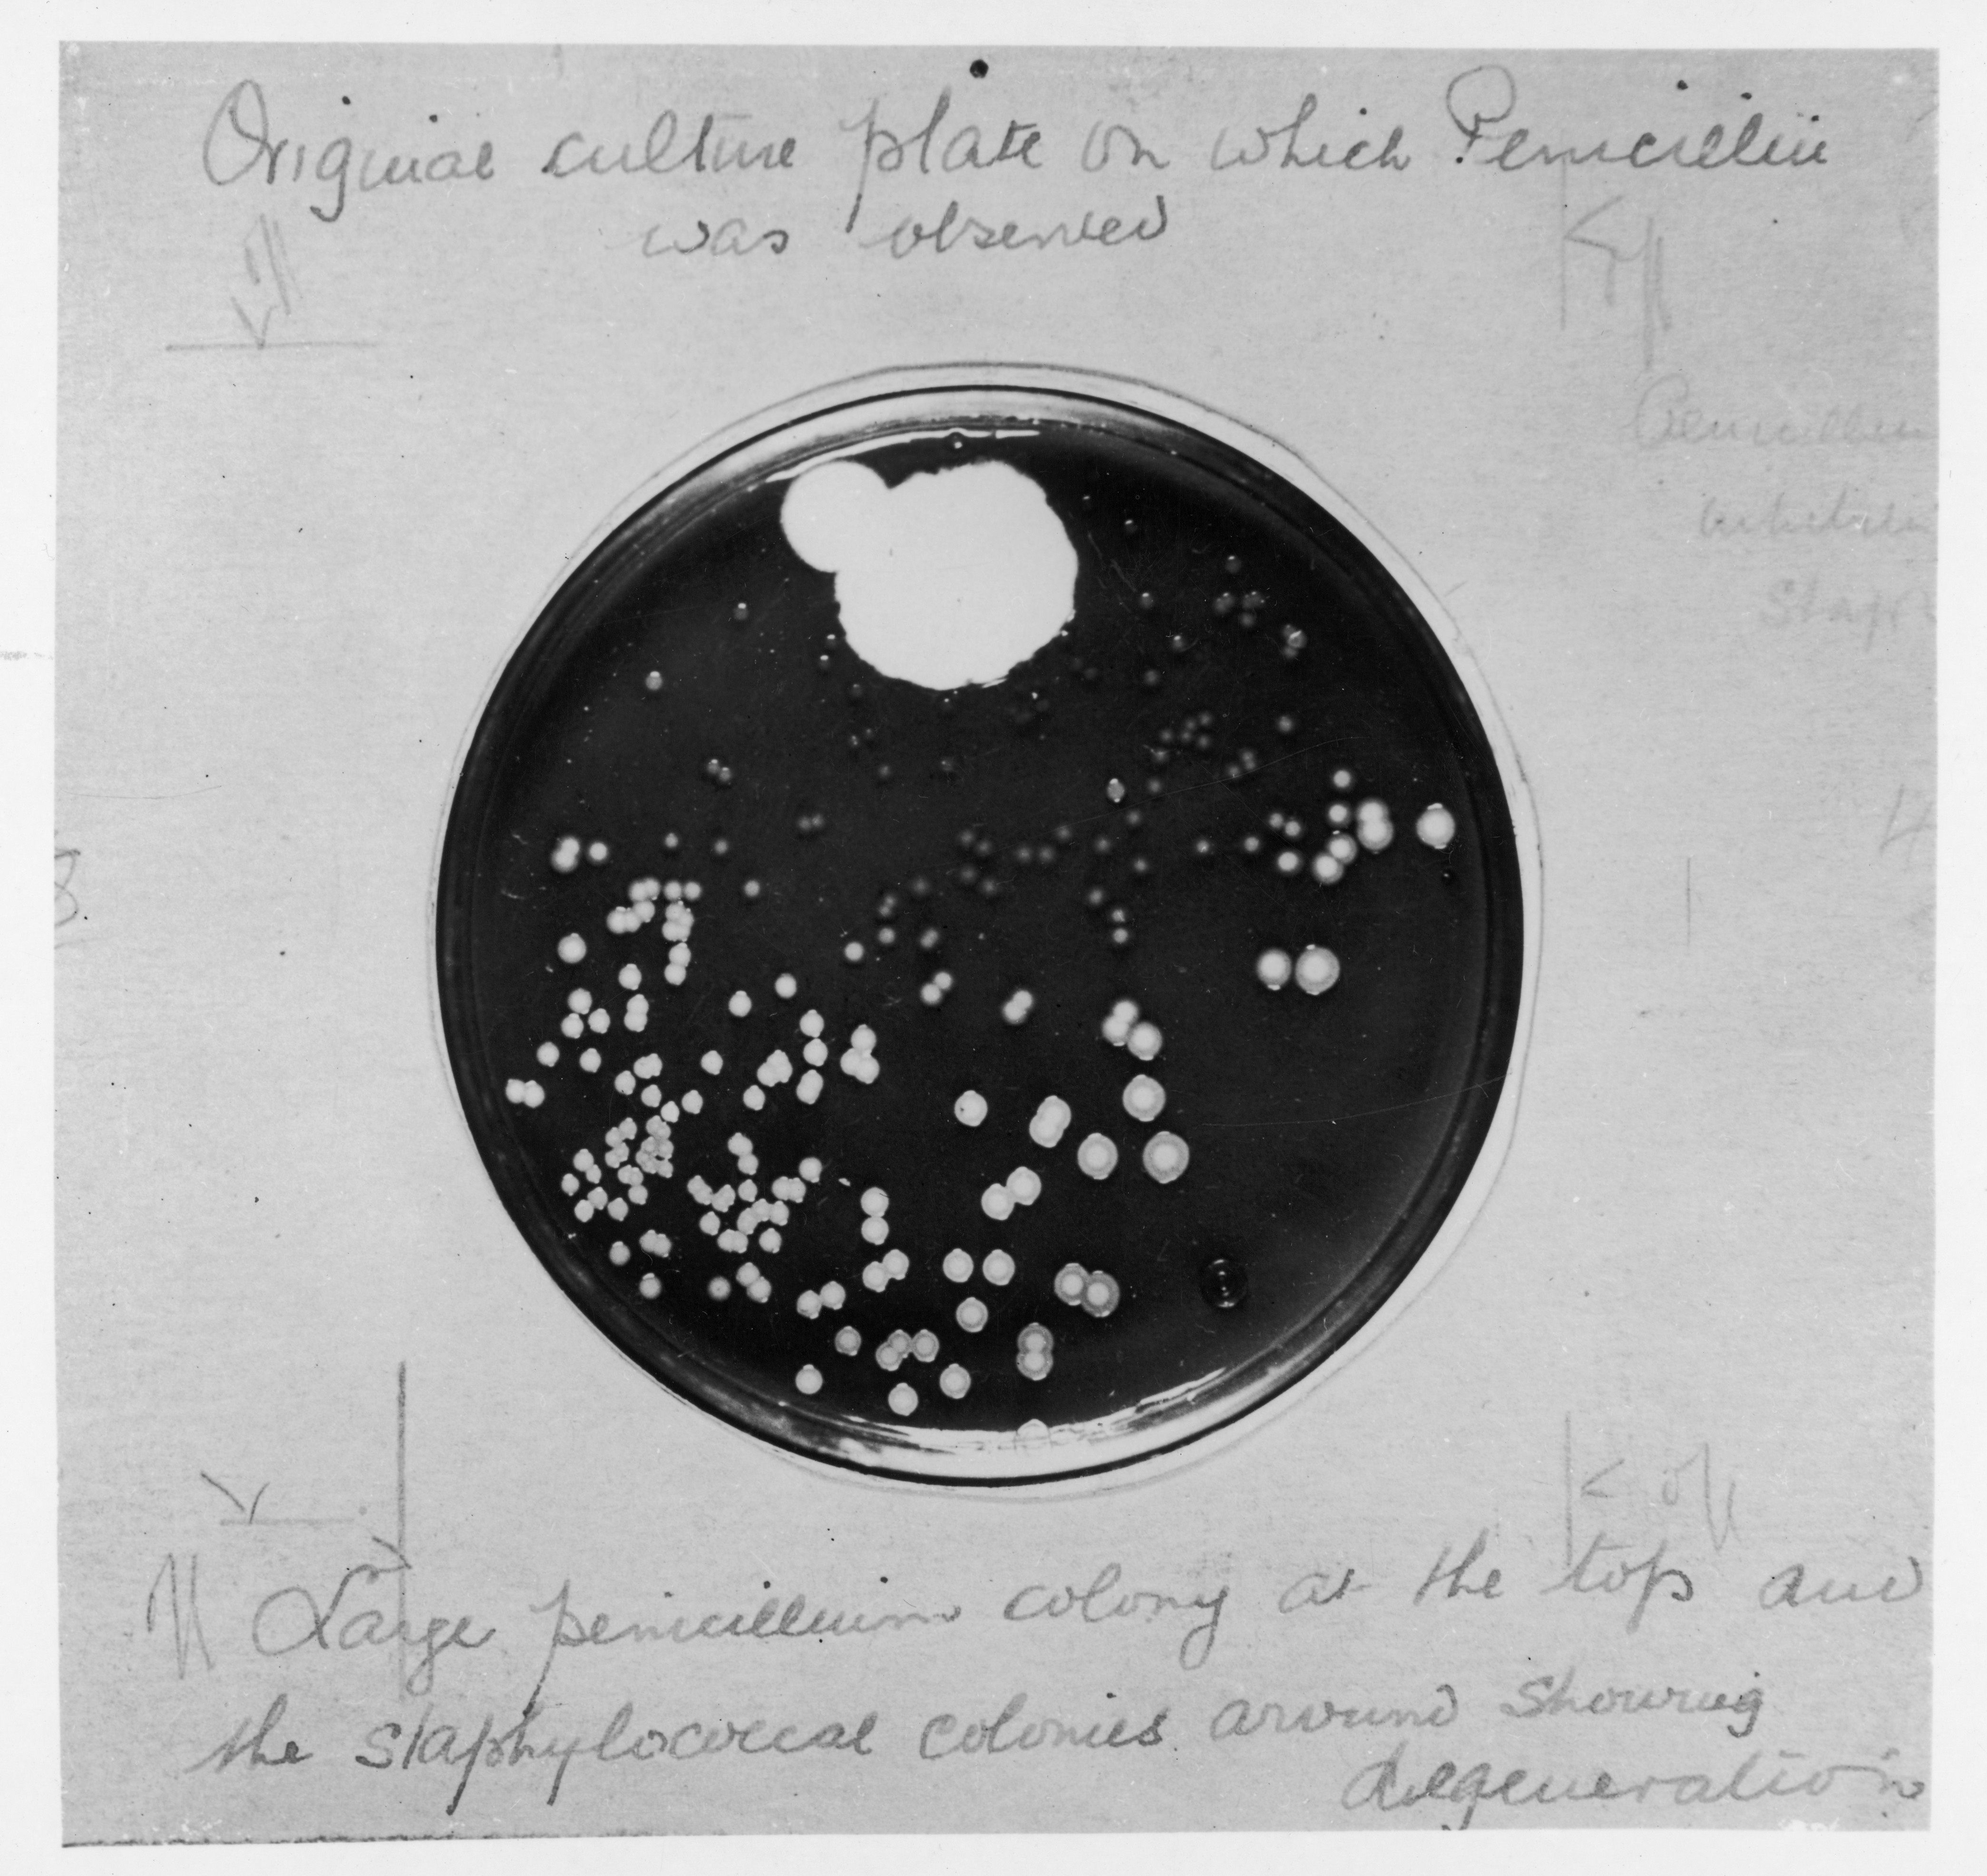
Safely evaluating penicillin allergy with 2-step Graded Oral Challenge | Image Credit: © Archivist - © Archivist - stock.adobe.com.

Review some of the top stories from the Contemporary OB/GYN website over the last week, and catch up on anything you may have missed.

Review some of the top stories from the Contemporary OB/GYN website over the last week, and catch up on anything you may have missed.

The Centers for Disease Control and Prevention's latest report unveils a 222% rise in maternal syphilis cases per 100,000 live births from 2016 to 2022, with increases observed across racial, age, and perinatal care groups nationwide.
Recent findings revealed the efficacy and safety of the 2-step Graded Oral Challenge method in assessing penicillin allergy risk, offering a promising approach for improved patient care and antibiotic stewardship in low-risk individuals.

Adolescent pregnancy and sexual health care utilization declined during the COVID-19 pandemic, indicating significant disruptions in reproductive health services for young females, as highlighted in a recent study published in Pediatrics.

Disparities in prenatal care and missed opportunities for diagnosis highlight the need for innovative approaches to tackle the rising prevalence of congenital syphilis, emphasizing standardized screening, higher quality diagnostics, and therapeutic interventions.

A recent report from the Centers for Disease Control and Prevention outlined methods of detecting syphilis in patients, including nontreponemal tests, treponemal tests, and nonspecific antibodies.

A recent study found that transgender women with HIV face elevated risks of bacterial sexually transmitted infections, emphasizing the need for tailored interventions and further research to address the distinct challenges faced by this population.

A new study set out to increase testing for chlamydia and gonorrhea for adolescents who presented to a pediatric emergency department with at-risk complaints.

Explore the Center for Disease Control of Prevention’s latest report on sexually transmitted infections, emphasizing the critical need for prioritizing STIs in public health.

Investigators recently noted that despite a decrease in adolescent hospital visits during the height of the pandemic, there was an increase in sexually transmitted infections (STIs) in this population group.

Review some of the top stories from the Contemporary OB/GYN website over the last week, and catch up on anything you may have missed.

A recent study explores how changing sexual behaviors influence rising sexually transmitted infection rates, underscoring the need for comprehensive prevention strategies.

The FDA emphasized the need for cautious herpes simplex virus type 2 serological testing, highlighting factors that increase the likelihood of false positives and urging adherence to CDC guidelines.

A 755% increase in reported cases since 2012 highlights the need for timely testing and treatment to prevent maternal and infant health risks.

In a recent study, high rates of reinfection were seen among patients who tested positive for Trichomonas vaginalis.

In a recent study, certain sexually transmitted infections were more common among patients positive for bacterial vaginosis.

The new lab will help prevent the spread of sexually transmitted infections in the United States.

Jonathan Miller, MD, pediatrician and chief of primary care, pediatrics at Nemours Children’s Health in the Delaware Valley, spoke about the latest data regarding early human papillomavirus (HPV) vaccination in children as young as 9 years old at the 2023 Pediatric Academic Societies meeting. He also provided some clinical pearls for opening the conversation with patients’ caretakers regarding earlier HPV vaccination.

In a recent study, doxycycline use reduced the incidence of sexually transmitted infections among transgender women and men who have sex with men.

Yasaswi Kislovskiy, MD, MSc, ob-gyn and reproductive infectious disease specialist, Allegheny Health Network, Pittsburgh, Pennsylvania, discusses the stigma around STDs/STIs and how clinicians can help spread awareness amongst their patients and their community.

The cumulative probabilities of treatment initiation after meeting the criteria was not significantly different between the different racial groups and the incidence of major adverse liver outcomes was 0.1 per 100 person-years and did not differ by race.

Investigators performed an economic evaluation of the HOME trial, which found increased rates of screening when human papillomavirus (HPV) self-sampling kits were mailed to participants, and found this process was cost-effective compared to usual care.

The patient, referred to as the “New York patient,” was treated with stem cells from cord blood, and has remained HIV-free in her blood since her transplant in 2017.

In a recent review, children with vaccination against human papillomavirus (HPV) initiated at a younger age were more likely to receive their full vaccination series.

Visby Medical has announced its second generation point of care test for detecting sexually transmitted diseases in women has received 510(k) clearance and a CLIA waiver from the FDA.